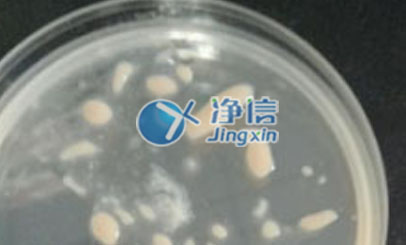

Brand speciality:
1. There is a lot of experimental data, and the paper search shows that it has exceeded 1184 papers.
2. Has more than eight patents related to grinding, focusing on the research and development of sample pretreatment.
3. The diameter of the main shaft of the central movement is greater than 10 mm, which is directly sold by the factory, not an OEM factory.
4. Reliable after-sales service, there are offices all over the country to contact at any time 24 hours a day.
5. It has the ability of continuous research and development and upgrading, which can ensure continuous technical update.
6. It can provide solutions for various samples and different grinding solutions to meet the needs of subsequent experiments. For example, planetary, horizontal, vertical up and down, three-dimensional motion, three-dimensional centrifugal motion, cyclone, disc, cyclone and other grinding solutions.
New Features:
The new generation of JXSTPRP? automatic tissue grinder adopts imported motors, anti-corrosion materials, and enhanced motion shafts. The performance is fully optimized, the appearance is more beautiful, and it brings you a different grinding experience!
Product description:
Automatic sample rapid grinder JXFSTPRP-L series, imported motor, anti-corrosion material, enhanced motion shaft and other upgrades. It can grind, pulverize, mix and break cell walls in a very short time. Special three-dimensional integrated vibration mode, more perfect grinding method, more thorough sample grinding and better stability.
Product Usage:
1. Suitable for grinding and crushing of various plant tissues including roots, stems, leaves, flowers, fruits, seeds and other samples;
2. Suitable for grinding and crushing various animal tissues including brain, heart, lung, stomach, liver, thymus, kidney, intestine, lymph node, muscle, bone and other samples;
3. Suitable for grinding and crushing of fungi and bacteria including yeast, Escherichia coli and other samples;
4. Suitable for grinding and crushing of food and medicine;
5. Suitable for grinding and crushing of volatile samples including coal, oil shale, wax products, etc.;
6. Suitable for grinding and crushing of plastics, polymers including PE, PS, textiles, resins and other samples.

Operating procedures:

Features:
1. Good stability: the three-dimensional integrated figure-8 oscillation mode is adopted, the grinding is more sufficient, and the stability is better;
2. High efficiency: complete the grinding of 2×24, 2×48, 4×96 samples within 1 minute;
3. Good repeatability: the same tissue sample is set to the same procedure to obtain the same grinding effect;
4. Easy to operate: built-in program controller, which can set parameters such as grinding time and rotor vibration frequency;
5. High safety: with safety cover and safety lock;
6. No cross-contamination: it is in a fully enclosed state during the grinding process to avoid cross-contamination;
7. Low noise: During the operation of the instrument, the noise is less than 55dB, which will not interfere with other experiments or instruments.
Performance:
Parameters | Parameter range |
Application | Tissue homogenization, grinding, cell disruption, homogenization, material dispersion, preparation, sample mixing, shaking |
Compatible sample size | Grinding tubes of various specifications can be customized according to requirements |
Feed / discharge size | There is no requirement for feeding, according to the size of the adapter; the discharge size of the discharge is ~5um |
Homogenization speed | 10—70 HZ/S |
Grinding Ball Material | Alloy steel, chrome steel, zirconia, tungsten carbide, quartz sand |
Grinding method | Wet grinding, dry grinding, cryogenic grinding |
A variety of adapters are available | Normal temperature adapter, low temperature adapter, liquid nitrogen refrigeration adapter, etc. |
Preset multiple sets of experimental data | According to different experimental samples, different parameters can be set |
Anti-vibration principle | JXFSTPRP-1 anti-vibration principle, and a special three-dimensional vibration mode of up and down and left and right shaking |
Grinding ball diameter | 0.1-30mm various options |
Dimensions | 400*500*580 |
Weight | 55KG |
Cooling function | Yes |
Basic configuration of automatic sample fast grinder:
1. One host: one JXFSTPRP-24L? host
2. Adapter: 2ml adapter (including refrigeration) two sets
3. Grinding tube: 500 grinding tubes for z
4. Grinding balls: one bottle of alloy steel/zirconia grinding balls
Precautions:
1. The instrument should be placed in a dry and ventilated environment;
2. The working voltage of the instrument is 220V;
3. When using liquid nitrogen, protective measures should be taken to prevent frostbite;
4. Fix the adapter before grinding, tighten the vertical positioning screw, and fasten the safety lock;
5. The samples should be placed as symmetrically as possible to ensure the force balance during grinding;
6. After grinding, please turn off the power and return the safety lock;
7. Clean the adapter regularly to prevent the residual medicine or sample from corroding it.